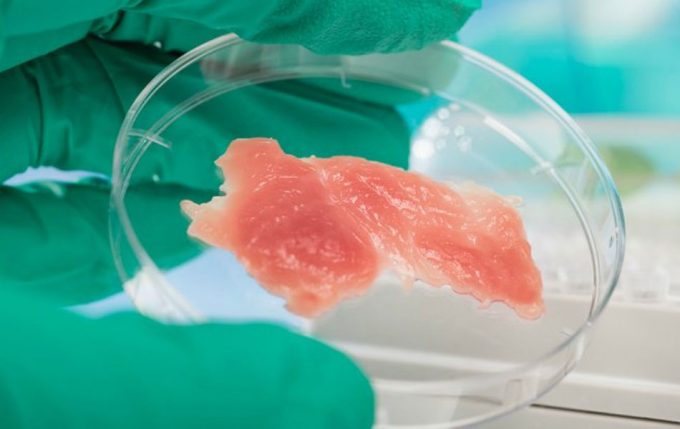

El CEO de Memphis Meats, empresa que trabaja para la producción de la carne de laboratorio o carne limpia y sostenible (como la definen), se ha aliado con Barry Carpenter del Instituto de Carne de América del Norte (The North American Meat Institute), asociación sin ánimo de lucro que representa los intereses de la industria cárnica y avícola proporcionando a sus asociados orientación y asesoramiento a envasadores y procesadores de carne, para escribir una carta en la que solicitan a Donald Trump que medie para establecer las regulaciones en la carne de laboratorio.
En la carta se explica que tanto la FDA (Agencia de Medicamentos y Alimentación de Estados Unidos) como el USDA (Departamento de Agricultura de Estados Unidos), tienen un papel en la regulación de la carne de cultivo o carne producida a partir de células animales. Por tanto, para asegurar que el sistema regulatorio pueda proteger a los consumidores a la vez que se fomenta la innovación en este sector, es imperioso que estas dos agencias colaboren y coordinen sus esfuerzos poniéndose de acuerdo en un marco regulatorio.
Recordemos que hace unos meses la FDA declaró que no veía la necesidad de llevar a cabo nuevas regulaciones para la carne de laboratorio. Por otro lado, la Asociación de Ganaderos de Estados Unidos (USCA) había solicitado al USDA que llevará a cabo una regulación de la carne de cultivo porque consideraba que este tipo de carne no procedía del sistema de ganadería tradicional, donde los animales nacen, son criados y sacrificados para el consumo humano, y por lo tanto, no se puede denominar “carne” el producto que ofrecen empresas como Memphis Meats.
Según la carta, ambas agencias tienen funciones en la regulación de la carne limpia y sostenible, de ahí que se solicite que las dos colaboren en beneficio de los consumidores y la innovación de la industria alimentaria. Como representantes de esta floreciente industria, comentan que no se pueden comprometer con la seguridad de los productos que desarrollan y reconocen la importancia de proporcionar la máxima transparencia a los consumidores, apoyan un mercado justo y competitivo que permita a los ciudadanos decidir qué productos alimentarios son los que más les convienen según sus creencias y convicciones, algo que el marco regulatorio existente puede brindar.
Con una llamada al patriotismo y a seguir con lo declarado por el presidente Donald Trump, “hacer que Estados Unidos vuelva a ser grandioso”, en la carta se comenta que Estados Unidos es actualmente el líder mundial en la producción de proteínas, incluidas las carnes obtenidas a partir de células vivas, pero no se puede mantener una posición definida sin un marco regulatorio. Por ello se pide respetuosamente una reunión entre la Casa Blanca, la FDA y el USDA, además de las partes interesadas de la industria cárnica y avícola convencional, y las empresas que trabajan en el desarrollo y producción de la carne de cultivo.

La carta concluye que se espera contar con “mentes abiertas” para solucionar esta cuestión para que la industria de la carne limpia y sostenible, sea capaz de dar el siguiente gran paso, abordar el mercado minorista, algo que apuntan que resultará muy beneficioso para el medioambiente, el bienestar animal y la economía del país, ya que son varios los estudios que se han realizado en los que se concluye que a un elevado porcentaje de estadounidenses les gustaría consumir carne sin que se sacrificasen animales, así como llevar a cabo una prohibición de la actividad de los mataderos.
Hay que apuntar que Memphis Meats despertó el interés de los magnates Bill Gates y Richard Branson, y Tyson Foods, el procesador de carne más grande del mundo, decidió hace unos meses realizar una inversión de 150 millones de dólares en Memphis Meats. Pero este es sólo un ejemplo, cada vez más compañías dedicadas a la producción de carne tradicional invierten en la denominada carne de cultivo o carne limpia y sostenible. Esto no ocurre sólo en Estados Unidos, también en Europa, al respecto se puede citar la asociación entre el Grupo PHW, uno de los productores más importantes de Europa de aves de corral, y la empresa startup israelí Supermeat, centrada en la investigación y la producción de carne de pollo in vitro.
Dado que no se tardará mucho en empezar a producir y hacer llegar la ‘carne limpia’ a los mercados, es obvio que se pida solucionar cuanto antes el marco regulatorio de la carne de cultivo, y ante las dispares posturas del USDA y la FDA, tiene sentido que se pida la mediación de la Casa Blanca (en este enlace (Pdf) podéis leerla). Es difícil creer que Donald Trump, medie y ayude en la regulación de la carne de cultivo, sobre todo porque posiblemente tenga contactos y amigos en el sector de la carne tradicional que no quieren que el nuevo producto pueda denominarse ‘carne’, pero es mejor no adelantar acontecimientos y esperar a conocer la respuesta del presidente estadounidense (si la hay).
La carta es una iniciativa llevada a cabo a raíz de una carta anterior enviada por los productores de carne tradicional a Donald Trump, solicitándole que sea el USDA y no a la FDA, la agencia responsable de supervisar y regular la carne cultivada, algo lógico porque el USDA vela especialmente por los intereses de los productores de carne tradicional.








1 comentarios
Mala idea pedirle a un político que intervenga. Muy mala.